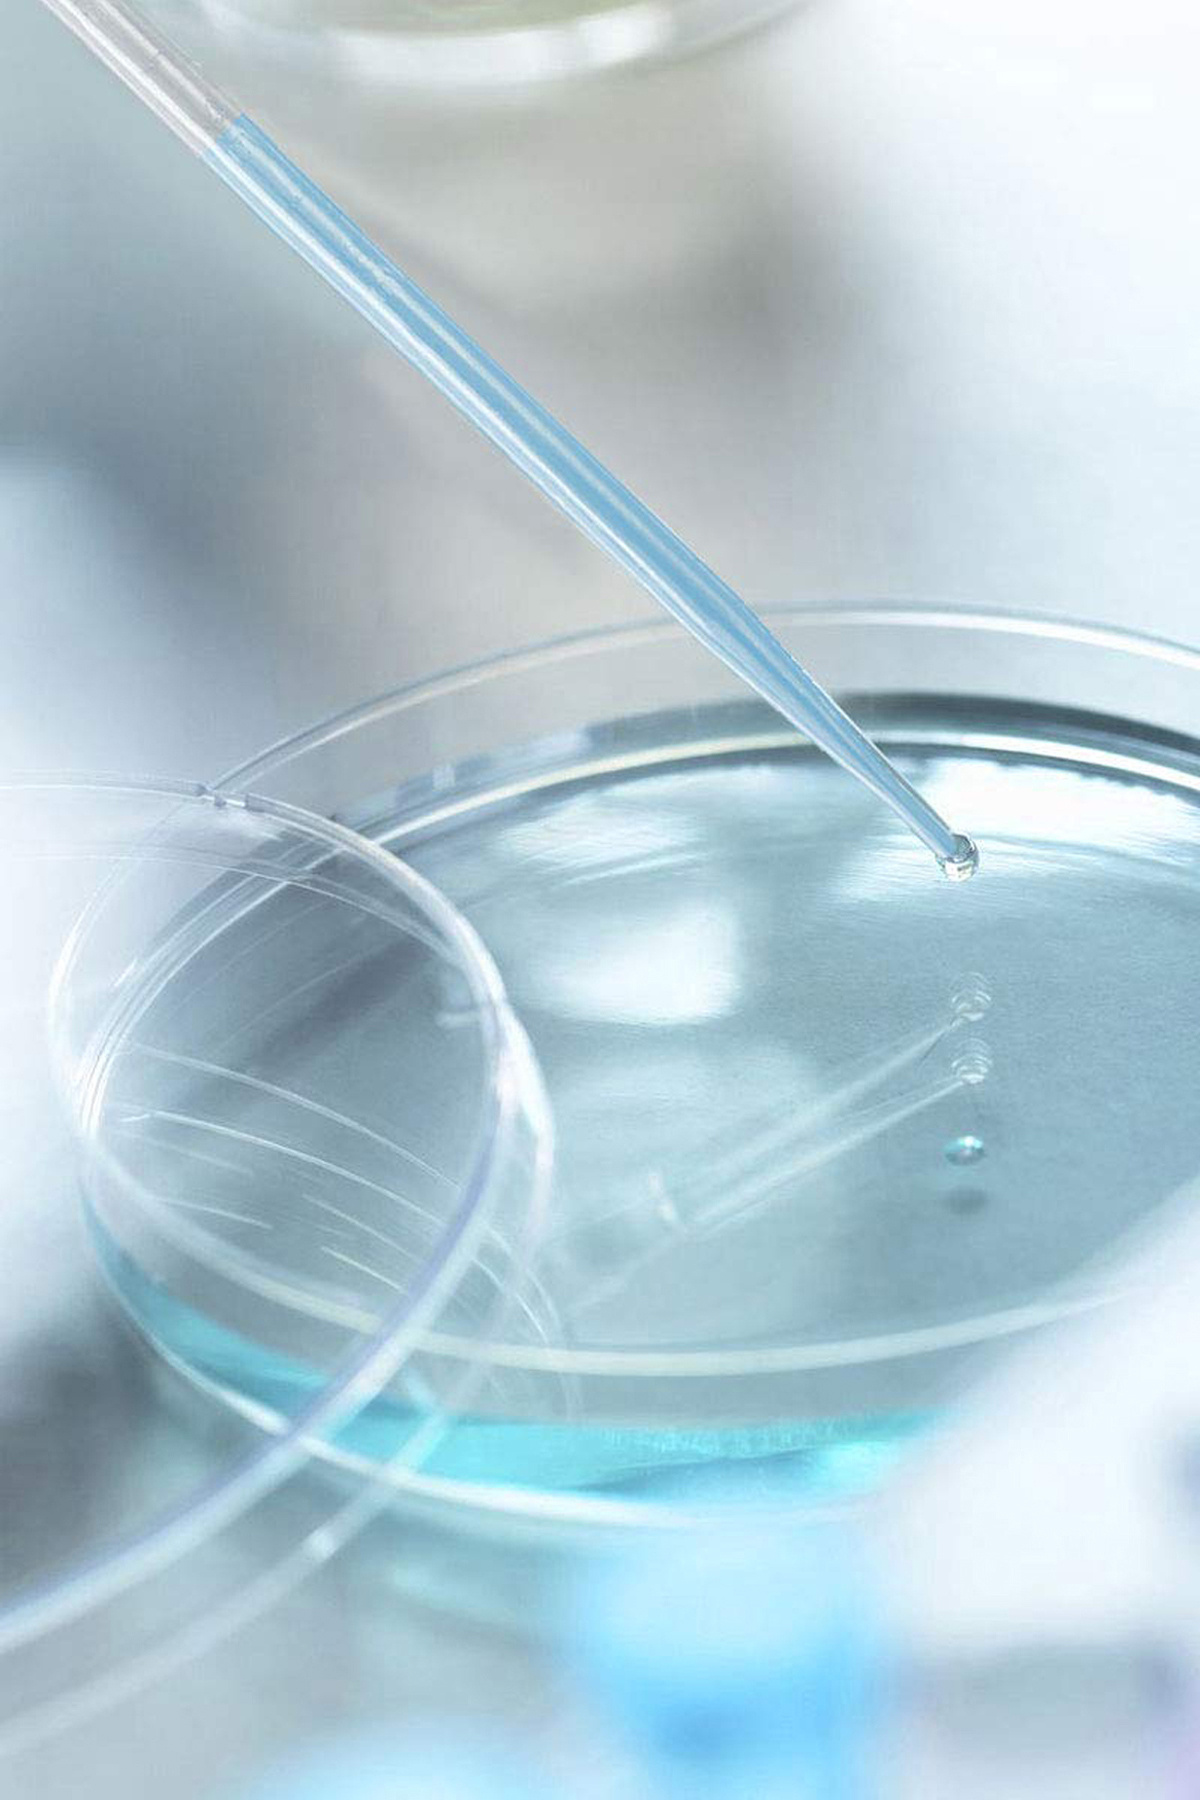
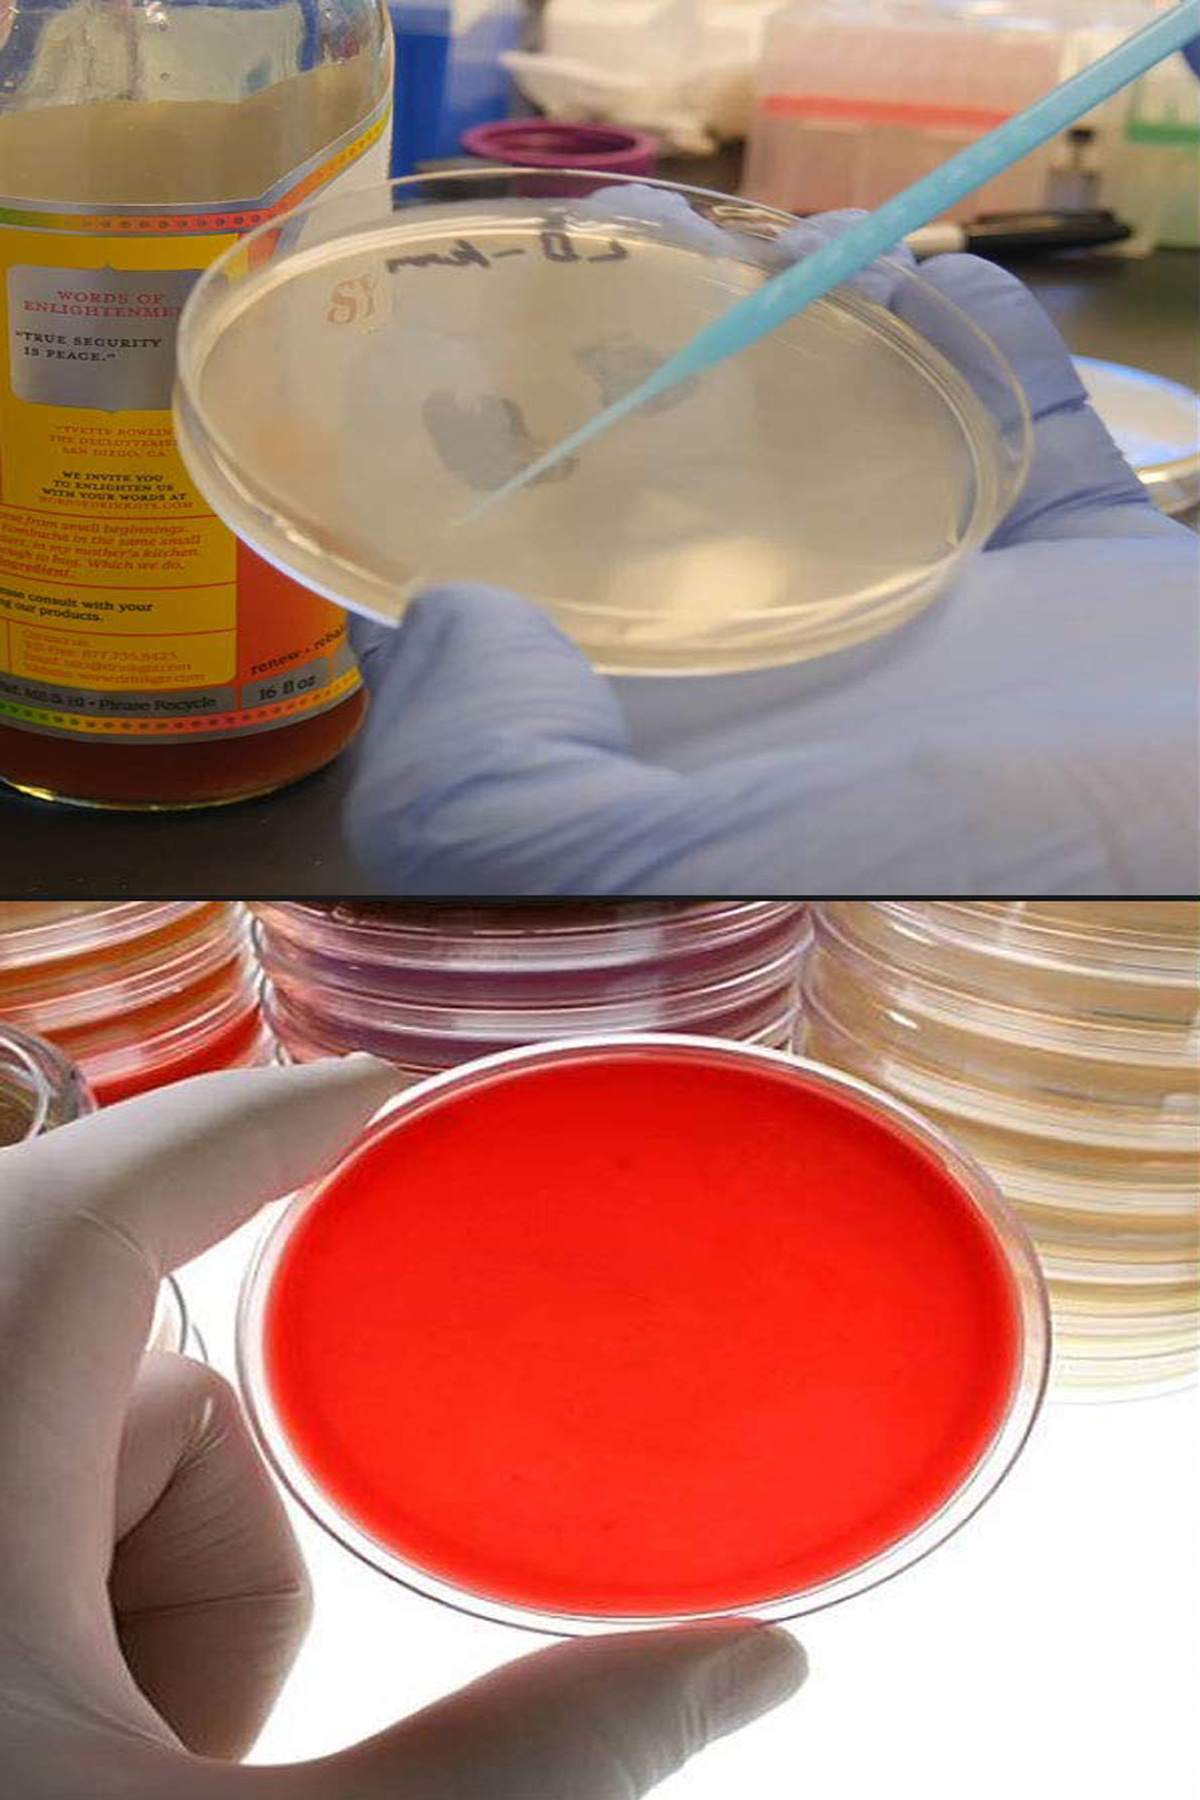

Petri Kabı Kutusu Plastik 90 X 15 Mm - 10 Adet
(21
المراجعات)
تم بيعها من قبل
ATEL-SAN LABORATUAR MALZEMELERİ ŞTİ. ( TR )
السعر
21.88 LYD
/unit
شارك

- Kampanya fiyatından satılmak üzere 10 adetten fazla stok sunulmuştur.
- Bir ürün, birden fazla satıcı tarafından satılabilir. Birden fazla satıcı tarafından satışa sunulan ürünlerin satıcıları ürün için belirledikleri fiyata, satıcı puanlarına, teslimat statülerine, ürünlerdeki promosyonlara, kargonun bedava olup olmamasına ve ürünlerin hızlı teslimat ile teslim edilip edilememesine, ürünlerin stok ve kategorileri bilgilerine göre sıralanmaktadır.
- Ürün Açıklaması: Mikrobiyoloji, bakteriyoloji ve benzer çalışmalarda kullanılmak üzere son derece şeffaf polistirenden üretilirler.
- Aseptik ortamda GMP'ye göre üretilmiş, sterilite kontrolleri yapılmıştır.
- Özel kapak tasarımları sınırlı hava akımını sağlayarak verimliliği artırır.
- Otoklav için uygun değildir.
- Kullanım Alanları: Biyoloji ve Mikrobiyoloji deneylerinde organizma ve kültür yetiştirmek için kullanılır.
- Ürün Ölçüsü: Çap: Ø 90 mm, Yükseklik: 15 mm - 10 Adet
المنتجات المشابهة
Dinamometre (1 Kg'lık)
34.23 LYD
AMONYAK (%25 D= 0.91) 1000 ML AMB.
37.20 LYD
Hemostatik 20 cm Pens Düz Paslanmaz
74.25 LYD
Saf Lanolin ( Yün yağı ) Hammadde 100 g
38.77 LYD
Saf Borik Asit Tozu – 1 kg
46.74 LYD
Glisin Toz 1 KG
67.06 LYD
BORIK ASIT %100 SAF E284 500 GR
15.16 LYD
TURNUSOL KAĞIDI - MAVİ
23.45 LYD


















![wellLine 30 Cc Cam Damlalıklı şeffaf Şişe [30 Cc=30ml X 10 Adet] / Ecza Şişesi / Dropper Şişe wellLine 30 Cc Cam Damlalıklı şeffaf Şişe [30 Cc=30ml X 10 Adet] / Ecza Şişesi / Dropper Şişe](https://cdn.dsmcdn.com/ty1547/product/media/images/ty1547/prod/QC/20240915/10/b25d76dc-5af6-35c8-92b9-d511d0c77fc0/1_org_zoom.jpg)
![wellLine 30 Cc Cam Damlalıklı şeffaf Şişe [30 Cc=30ml X 10 Adet] / Ecza Şişesi / Dropper Şişe gümüş renk kapk wellLine 30 Cc Cam Damlalıklı şeffaf Şişe [30 Cc=30ml X 10 Adet] / Ecza Şişesi / Dropper Şişe gümüş renk kapk](https://cdn.dsmcdn.com/ty1543/product/media/images/ty1546/prod/QC/20240914/22/4e06f396-033c-3325-9504-04324cad518e/1_org_zoom.jpg)




